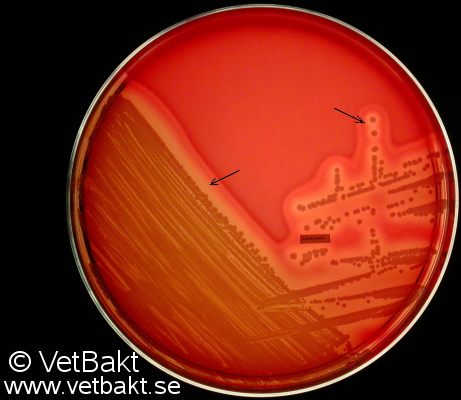
<i>Staphylococcus pseudintermedius</i>

Staphylococcus pseudintermedius
Fig. 135:1. Colonies of Staphylococcus pseudintermedius, strain VB 001/09, cultivated aerobically for 24 h on bovine blood agar at 37°C. Note the double zone of hemolysis. The arrows indicate the border between the first and second hemolysis zone (complete and partial hemolysis, respectively). The complete hemolysis is caused by an α-hemolysin and the partial by a β-hemolysin.
Credit: Karl-Erik Johansson (BVF, SLU & SVA) & Lise-Lotte Fernström (BVF, SLU).

This work is licensed under a Creative Commons Attribution 2.5 Sweden License.

